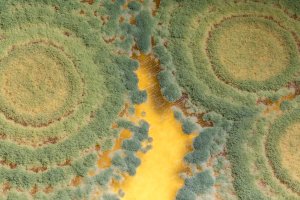
El secreto del éxito de Trianum es un hongo beneficioso apto para todo tipo de suelos

Entrenamiento del Almería 23 de abril
Rafa Góngora

Rafa Góngora

Javier Romero
Los 30 nombres que acompañarán a Joaquín Pérez de la Blanca el 26M

Pedro Lamazares
Elegantes multitalento con genes de bólidos de competición
La Voz
El fungicida biológico de Koppert es muy eficaz y está autorizado en agricultura ecológica

Eva de la Torre, La Voz
La cocaína se producía en Puente-Tocinos y se ocultaba en Almería en pequeños ‘zulos’

La Voz
La Comandancia de la Guardia Civil de Almería ha servido de escenario

La Voz
Pide una reducción en los índices de rendimiento neto para la renta agraria

Carlos Miralles
El Número 3 del mundo en pádel se ejerita en Almería

Guillermo Mirón, La Voz
La lista está liderada por el exalcalde carbonero Salvador Hernández

La Voz
Asistieron más de medio centenar de representantes del sector hortofrutícula de la costa
Jose Fernández
Pedro Mena Enciso
La Voz
La Voz

La Voz
La Consejería facilita la asistencia a la feria Siam Meknes


La Voz
Educación y Deporte informa a la Mesa Sectorial


Guillermo Mirón, La Voz
La AMPA del centro asegura que unas 30 solicitudes de nuevos alumnos “quedarían sin plaza”

Antonio Fernández
Declaraciones del secretario general del Ministerio de Agricultura
Más leídas